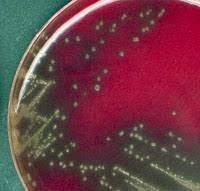
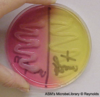
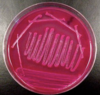
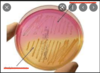
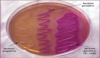

VRAI OU FAUX? La très grande majorité des microorganismes sont offensifs
Faux. la très grande majorité sont inoffensifs.
Quel est l’endroit où renferme la plus grande variété de microorganismes
Le sol.
Ensemble de microorganismes présents dans un milieu donné et à un moment donné.
Une flore
VRAI OU FAUX? l’air ne renferme pas de flore naturelle.
Vrai. Les microorganismes ne peuvent pas croitre dans l’air.
Qu’est-ce qu’une flore commensale?
flore chez les animaux, présente naturellement sur la peau, les poils, voies respiratoires, digestives, génitales… Un lavage ne les enlève pas.
Qu’est-ce qu’une culture mixte?
Plusieurs espèces de microorganismes croissent sur le même milieu de culture.
Qu’est-ce qu’une colonie?
Le résultat visible à l’oeil de la multiplication d’une seule bactérie.
Le nombre de colonies est représentatif du ____________ de l’échantillon prélevé.
du nombres de bactéries.
Qu’est-ce que la technique du repiquage?
Isoler une espèce de bactérie en touchant un seule colonie avec un fil de platine stérile et en déposant le prélèvement sur un autre milieu de culture.
Qu’est-ce qu’une culture pure
Les caractéristiques de la colonie d’une espèce de bactérie sont constantes sur un milieu donné et peuvent aider à l’identification
Pourquoi est-il intéressant de travailler avec des gléloses de sang?
Certaines bactéries produisent des hémolysines, ce qui détruit les globules rouges. Ce phénomène s’appelle hémolyse. Sert à l’identification des pathogènes hémolytiques de type alpha et bêta.
Qu’est-ce qui démontre une hémolyse partielle de type alpha?
la zone autour des colonies devient verdâtre et translucide.
Qu’est-ce qui démontre une hémolyse totale de type bêta.
Zone transparente autour de la colonie.

Quelle gélose a-t-on utilisé pour l’ensemencement des microorganismes du sol?
gélose Sabouraud
Si nous voulons ensemencer un échantillon sec, quelle étape devons-nous faire?
Humidifier le frotti avec de l’eau stérile
Qu’est-ce qu’un milieu?
Le support de la croissance microbienne
Qu’est-ce qui limite la croissance des microorganismes?
- l’épuisement en ressources nutritives du milieu
- Accumulation de déchets métaboliques et de sous-produits toxiques
- Acidification du milieu
Quelles techniques peuvent être utilisé afin de séparer des microorganismes?
- technique d’épuisement
- technique de dilution
Sur quelle principe repose l’isolation de microorganismes?
Séparer les cellules de microorganismes les unes des autres lors de l’ensemencement de l’échantillon de façon à isoler des cellules individuelles sur ou dans un milieu solide
Quels types de caractéristiques permettent de distinguer un type particulier de colonie sur une gélose?
- plus ou moins élevée
- bordure plus ou moins découpée
- forme plus ou moins définie
Quels types de caractéristiques permettent de distinguer une croissance de microorganismes sur un bouillon de culture?
- turbidité
- formation de dépôt
Quand faut-il passer le tube du bouillon de culture à la flamme?
Avant et après chaque prélèvement.
Quand faut-il passer le fil de platine à la flamme?
Avant et après chaque prélèvement.
Pourquoi faut-il agiter le tube contenant le bouillon d’Escherichia coli
Car ceux-ci peuvent se déposer au fond